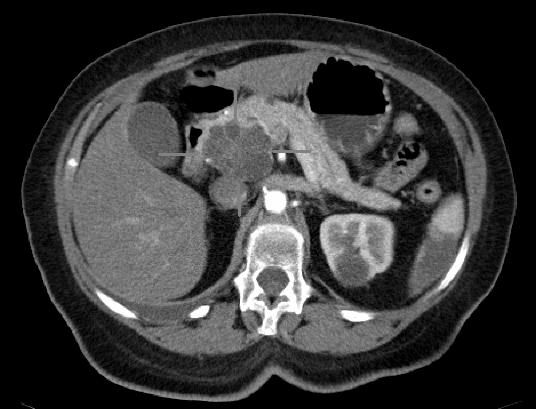
【Cell子刊】发现胰腺癌细胞中触发转移性的“分子开关”

推荐活动

【直播】Twist 寡核苷酸池在生命科学中的创新应用:FOCAS--解析癌症中m6A修饰位点的全转录组功能
专家访谈

《转》访欧易生物总经理张志明:持续逆势快速增长!破解科研服务"不可能三角"的硬核逻辑

《转》访菲鹏数辉马步勇教授|AI与分子模拟引领生物医药创新,“构象选择机制”开辟药物动态设计新纪元

《转》访无锡市第九人民医院科教科主任赵刚

《转》访Olink亚太副总裁Andrea Ballagi博士:新一代蛋白组学如何加速精准医疗新进程

【我的2022】瑞普基因首席技术官王涛:发挥BT+AI双引擎特色优势,推进AI技术在精准医疗领域的临床落地

【我的2022】佰诺全景创始人焦磊:降低使用成本和难度,推动全景病理技术在中国的临床转化落地

【我的2022】墨卓生物创始人兼COO刘寒:日日精进,久久为功,把一个好的单细胞中国解决方案带给客户

【我的2022】迈杰医学董事长兼首席执行官张亚飞:数智化赋能商业模式转型,为客户提供更优质的伴随诊断整体解决方案

【我的2022】深圳绘云生物总经理林景超:专注慢病早筛类临床质谱检测产品,从临床痛点出发,为临床医学检验解决更多难题

【我的2022】艾吉泰康联合创始人屈武斌:对技术精雕细琢,以客户应用场景为核心,用特色服务提供基因捕获整体解决方案

【我的2022】恩泽康泰联合创始人李志:开放与合作,深耕外泌体技术开发与临床转化,为创新药研发提供坚实的肩膀!

【我的2022】迈迪安生命科学部门市场总监Liyan Pang:持续拓展颠覆性分子诊断原料,为体外诊断行业提供创新型解决方案
微适博®以循环肿瘤基因(ctDNA)为生物标志物,进行早期肿瘤根治性治疗分子残留病变检测,满足临床对预后评估的需求从而辅助临床进行治疗决策。
北京科学技术出版社于2022年6月出版,主编为中科院上海生命科学研究院李亦学教授和北京大学肿瘤医院张力建教授
最近,来自麻省理工大学的研究者们搭建了一个基于微流体技术的血管化模型,用以精准分析影响肝脏再生的关键因素。让我们一起来看看这款被称作SHEAR的模型具有什么特别之处。它是如何营造高水平肝脏组织环境?又是如何帮助研究者发现影响肝脏再生的关键因素——前列腺素E2(PGE2)?
运动可以甩掉我们身上“多余”的肉,也可以帮助肝脏“减肥”。来自上海体育大学运动机能学院的研究者发现,运动可以激活一种线粒体内膜蛋白的表达,进而加强脂肪酸氧化(FAO),缓解脂肪肝。此项由运动介导的分子机制,或将为肝脏脂质代谢紊乱提供新的治疗策略。
癌仍然是全球最致命的癌症,仍然是一个巨大的全球健康负担,非小细胞肺癌(NSCLC)约占所有肺癌的85%,大多数是在晚期诊断的。
癌症免疫疗法对一部分癌症患者来说,是具有变革性意义的存在。但对于大多数的患者,它的效果甚微,而通常的原因就是因为T细胞衰竭。由于长期暴露于持续性抗原或慢性炎症,T细胞逐渐失去效应功能,记忆T细胞特征也开始缺失,因而消灭癌症或病原体的力度会大打折扣。最近,有研究团队开发了一个T细胞衰竭模型,并使用基因编辑技术,测试哪些基因在触发T细胞衰竭中起着最至关重要的作用。
为了执行其无数的功能,免疫系统首先必须区分自我和非自我,如果免疫系统未能做出这种区分,就会错误地对身体发起攻击,引起自身免疫性疾病。但免疫细胞究竟如何学会区分朋友和敌人的?近期研究确定了一种新的机制,解释了T细胞如何学会区分自我和非自我。
乳腺癌的疾病分型多种多样,其中三阴性乳腺癌因预后极差被称为“乳腺癌之王”。整体乳腺癌的生存情况较其他癌症要好,但晚期三阴性乳腺癌的5年生存率仅为11%。很少有三阴性乳腺癌(TNBC)患者受益于免疫检查点抑制剂,完全和持久的缓解非常罕见。
美国有超过62,000人将在今年年底被诊断为胰腺癌,其中绝大多数有一种致命的侵袭性亚型被称为胰腺导管腺癌(PDA)。PDA影响90%以上的胰腺癌患者,平均5年生存率低于10%。近期研究发现MSRA表达水平在PDA细胞中作为原发癌生长和转移扩散之间的“分子开关”发挥作用,为切换这种分子开关来阻断疾病向其他器官的扩散的治疗方法提供关键见解。
主要修订内容如下:一、优化调整风险人员的隔离管理期限和方式,二、统一封管控区和中高风险区划定标准等
随着精准医疗时代的到来,多组学技术已成为生命科学研究领域的重要手段之一
6月24日,美国最高法院以6:3的投票结果,推翻了1973年最高法院关于“罗伊诉韦德”一案的判决先例,这意味着堕胎权将不再受美国宪法保护,女性健康及生殖健康权遭受重大威胁。在这个“残忍的决定、悲剧性的错误”发生后,我们还能做些什么?或者,首先应该思考什么?
随着Delta病毒和Omicron变体的出现,大多数的新冠疫苗和单克隆抗体已变得不再高效,因为刺突蛋白的突变帮助病毒免逃过抗体的识别。而在病毒内部的蛋白质中,相关的积累突变却少很多。这意味着对这些“非规范性抗原”进行靶向,或将增强疫苗及新冠治疗的效果,使身体产生更强大的免疫力。近日,一项新研究为此进行了探索。
嵌合抗原受体(CAR - T细胞)是一种突破性的免疫疗法,通过改变病人自身的免疫细胞来对抗癌细胞。这种疗法在治疗儿童和成人白血病和淋巴瘤,特别是在复发患者中,取得了显著的成功。然而,CAR - T细胞还没有在对抗实体肿瘤上取得同样的成功,它存在持续性和功能性的问题。最近,有研究团队探索了引导T细胞成为效应细胞和记忆细胞的机制,并发现了修改这一过程的关键因子
加州大学圣地亚哥分校的研究人员进行的一项研究显示,一种对抗癌症的新组合疗法可能由一种植物病毒和一种激活免疫系统的自然杀伤细胞的抗体组成。在结肠癌小鼠模型中,联合治疗消除了所有肿瘤,并阻止了它们的复发,进而获得了100%的生存率。该疗法还提高了黑色素瘤小鼠模型的存活率。
RSV是婴儿和免疫功能低下个体下呼吸道感染的主要原因,但没有有效的治疗方法。2015年,该病毒在全世界造成约3310万例病例,320万例住院治疗,并导致59,800人死亡。研究结果将AVG-388确定为主要候选药物,其有效地阻断了病毒RNA聚合酶的活性,RNA聚合酶是一种负责病毒基因组复制的酶。
6月22日,《药精准》系列第六期直播圆满结束,欢迎观看回放!
近期研究提高了蛋白质修复DNA氧化损伤的能力,并创造出一种新的蛋白质功能。他们的创新技术可能会导致针对涉及氧化应激的疾病,如癌症、老年痴呆症和肺部疾病的药物得到改进,但研究人员认为它具有更大的潜力。
与健康的心脏相比,“衰”的心脏的基因表达谱和转录谱有何不同?我们是否可以利用这种不同,来更好地理解不同种类的心力衰竭?这对心衰的精确化治疗及早期筛查有什么意义?为了探索这些问题,来自麻省理工学院布罗德研究所等机构的科学家们绘制了一张心脏单细胞基因图谱,对来自42个左心室样本的60万个细胞核进行了单核RNA测序(sNuc-seq),试图带我们走出心衰的重重迷雾。
热门活动
分享至:

-

第二届中国类器官转化医学大会
2025-11-14
时间:2025年11月14日-15日
地点:上海
[详情]
-

第六届单细胞技术应用研讨会暨空间组学前沿研讨会
2025-09-19
时间:2025年09月19日-20日
地点:北京京仪大酒店(北京海淀区大钟寺东路9号)
[详情]
-

第七届上海国际癌症大会
2025-06-12
时间:2025年06月12-15日
地点:上海
[详情]
-

中国转化医学产业大会 大咖论坛
2025-02-27
时间:2025年02月27日
地点:上海中油阳光大酒店(上海浦东东方路969号)
[详情]
-
最新原创
快捷导航
热门标签
订阅Newsletter
提交您的邮箱地址,我们会定期将电子期刊发送到您的邮箱
微信号:zhuanhuayixue,转化医学领域核心门户,提供优质原创内容,深度行业分析,最新资讯报道。
转化医学网视频号,更多有趣好玩儿、有观点、长知识的生物医药视频,欢迎观看!




 第二届中国类器官转化医学大会2025-11-14
第二届中国类器官转化医学大会2025-11-14 第六届单细胞技术应用研讨会暨空间组学前沿研讨会2025-09-19
第六届单细胞技术应用研讨会暨空间组学前沿研讨会2025-09-19 第七届上海国际癌症大会2025-06-12
第七届上海国际癌症大会2025-06-12 中国转化医学产业大会 大咖论坛2025-02-27
中国转化医学产业大会 大咖论坛2025-02-27 腾讯登录
腾讯登录